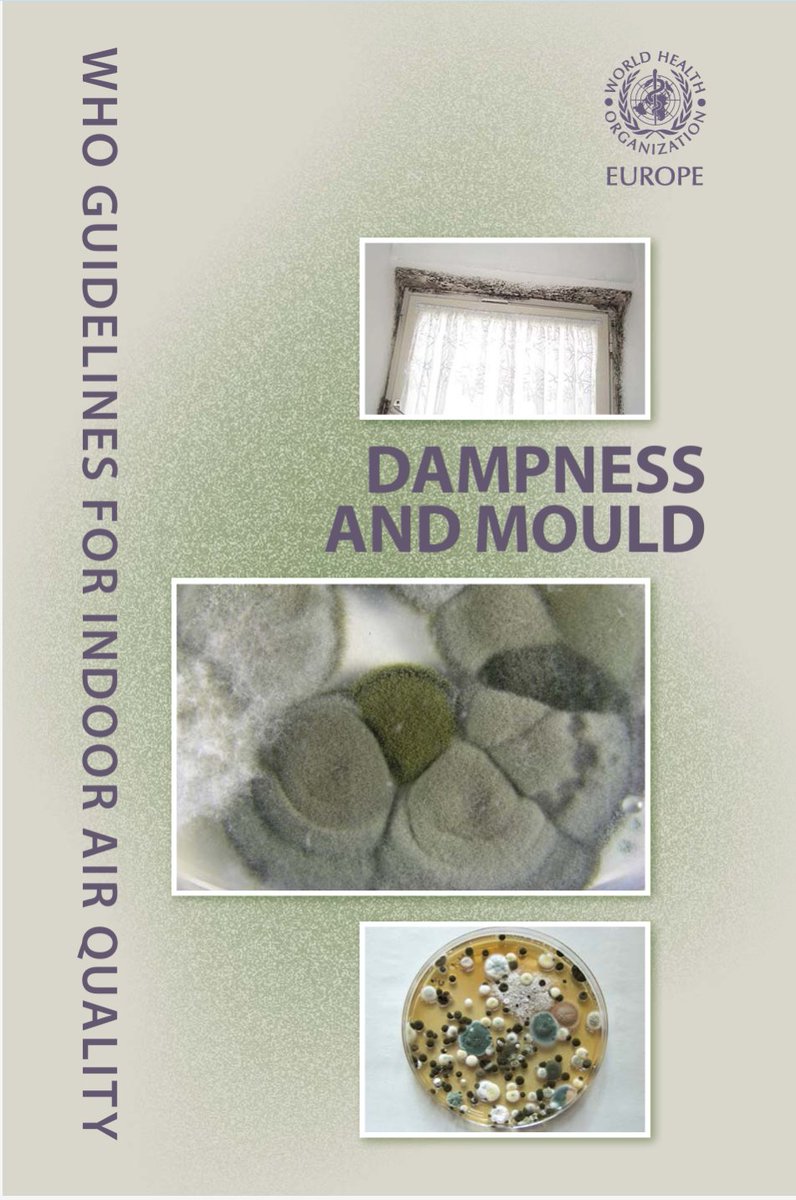
dosenkesmas's tweet image. "Kenapa didiagnosis Pneumonia padahal cuma di kamar? Jawabannya: Hypersensitivity Pneumonitis.

Kamar lembap = Sarang jamur &amp;amp; tungau. Pengharum ruangan = Volatile Organic Compounds (VOCs).

Kamar lembap + pengharum ruangan itu kombinasi maut. 🚨

Paru-paru kita nggak didesain…

Patrickisation
@spareofPatrick
Patrickisation is currently on a suspended state. Cut me pieces, then more of me coming up.
Testing. Sepertinya saya harus lebih lay low lagi dalam ngetweet
"Kenapa didiagnosis Pneumonia padahal cuma di kamar? Jawabannya: Hypersensitivity Pneumonitis. Kamar lembap = Sarang jamur & tungau. Pengharum ruangan = Volatile Organic Compounds (VOCs). Kamar lembap + pengharum ruangan itu kombinasi maut. 🚨 Paru-paru kita nggak didesain…

Kamar tidur wajib ada : Sirkulasi Udara (Jendela) Dehumidifier bukan Humidifier Air Purifier Ada yang didiagnosis pneumonia gara2 kamar lembab dan sering pake pengharum ruangan
Jaman covid, Opung literally ngecarry beban semua pemda. Pemda tuh kelabakan semua ngadepin covid (kecuali Jakarta). Infonya opung telponin satu-satu kepala daerah buat koordinasi, setiap pagi, setiap hari. Ini alasan kenapa Indonesia gak ambyar banget dihantem Covid
Serius nanya, LBP emang se skillfull itu? Kalo powerfull iyasih.
Kenapa Banyak Petani Menanam Pohon Turi di Pinggir Sawah? Di banyak desa pertanian, pohon turi (Sesbania grandiflora) sering ditanam di pematang sawah. Bagi petani lama, ini bukan sekadar kebiasaan, tapi bagian dari ilmu titen yang diwariskan turun-temurun. Dalam titen Jawa,…



"Mother of Disease" (Diabetes): Induk dari segala penyakit (kebutaan, gagal ginjal, jantung, stroke, hingga impotensi). Yuk kurangi konsumsi GULA sekarang.

Jambi ternyata jadi provinsi "paling manis" se-Indonesia! 🍭📈 Berdasarkan data SKI 2023, 61,8% warga Jambi makan manis tiap hari, disusul DIY (60,3%). Rata-rata nasional kita cuma 47,5%. Inget ya, yang manis emang enak, tapi kalau tiap hari bisa bikin tensi & gula darah…

AWOKAWOKAWOKAWOKAWOKAWOKAWOKAWOKAWOKAWOKAWOKAWOKAWOKAWOKAWOKAWOKAWOKAWOKAWOKAWOKAWOKAWOKAWOKAWOKAWOKAWOKAWOKAWOKAWOKAWOKAWOKAWOKAWOKAWOKAWOKAWOKAWOKAWOKAWOKAWOKAWOKAWOKAWOKAWOKAWOKAWOKAWOKAWOKAWOKAWOKAWOKAWOKAWOKAWOKAWOKAWOKAWOKAWOKAWOKAWOKAWOKAWOKAWOKAWOKAWOKAWOKAWOKAWOKAWOKAWOK…
Indonesia juga menyerukan kepada seluruh pihak terkait untuk mengedepankan penyelesaian secara damai melalui langkah-langkah de-eskalasi dan dialog, serta tetap mengutamakan perlindungan terhadap warga sipil.
Gak, ternyata gak cuma satu-dua-tiga anak dibawah umur yg lo perlakukan kaya kemaren, lo udah ngirimin mereka foto2 telanjang lo tanpa konsen dan memohon buat jd slave mereka, yang artinya lo memohon untuk ada interaksi sexual antara lo dan mereka? When they are just 16?????
Indonesia juga menyerukan kepada seluruh pihak terkait untuk mengedepankan penyelesaian secara damai melalui langkah-langkah de-eskalasi dan dialog, serta tetap mengutamakan perlindungan terhadap warga sipil.
AMERIKA SERIKAT MENYERANG VENEZUELA! Baru saja terjadi, Amerika Serikat akhirnya melancarkan aksi militer secara langsung di dalam wilayah kedaulatan Venezuela, langsung di jantung Ibu Kota Venezuela, Caracas. Serangan direkam oleh masyarakat Venezuela, terlihat unsur helikopter…
Full-scale military operations appear to be underway against Venezuela, with dozens of helicopters with the U.S. Army spotted over the capital of Caracas.
Maaf ya kak...🙏 Pernyataannya itu SEBAGIAN BENAR, tapi sering dibikin menakutkan tanpa konteks. Fakta ilmiahnya Genjer (Limnocharis flava) memang termasuk tanaman fitoremediator. Artinya : Dia mampu menyerap zat tertentu dari air dan lumpur, termasuk logam berat JIKA…
Ulat Gagak (Orthomorpha coarctata) Bukan Sekadar Bau Wengur, tapi Bahasa Alam dari Tanah. Di banyak daerah Jawa, hewan ini dikenal dengan nama “ulat gagak”. Tubuhnya hitam mengkilap, beruas-ruas dengan garis kuning cerah, jalannya pelan tapi konsisten, dan satu ciri yang paling…

‼️FWB INDONESIA COMEBACK🤍‼️ ‼️OPEN FOLLOWBACK DAN GRATIS MENFESS 1 X ‼️ Syaratnya : ❣️pastinya udah follow ❣️repost dan like post ini ❣️reply udah follow min ‼️Berlaku sampe besok malam jam 22:00 ya‼️

New year, NEW PANDEMI BABYYYYYYYYY
Kementerian Kesehatan mengungkap, varian influenza A ‘subclade K’ yang dikenal sebagai ‘super flu’ telah masuk ke Indonesia. Apa saja gejalanya? Geser slide-nya sampai habis, ya. | Narasi Daily

Eh anjing juga ini orangggg sialan
12. eh kayanya kita.. gpp yh kalau aku dan jutaan orang ini tau..


In this economy coy gila
Well done 🫡
Sumpah ini sih sakit
Ajg saking korupnya negara ini 🤣🤣🤣
Jangan jangan bahan terror dianggarkan kepala Babi, dikorup yang nyampe malah ayam.
Sumpah gajelas ege lu
Sumpah Gajelas
Disebut susu, tapi susunya cuma 1%. Sisanya air, gula, dan aditif pangan. Inilah contoh klasik kebijakan yang mengejar distribusi cepat, tapi mengorbankan substansi. Anak-anak dipaksa mengonsumsi minuman manis rendah nilai gizi, dan negara mendapat laporan “program gizi berjalan”

Semakin yakin diri ini untuk mikir bahwa kabinet periode ini emang buruk dan banyak orang titipan
United States Trends
- 1. Renee 600 B posts
- 2. Charlie Kirk 120 B posts
- 3. Trae 99,2 B posts
- 4. Macklin Celebrini 3.309 posts
- 5. hudson 259 B posts
- 6. #TheFutureIsTeal 2.049 posts
- 7. Hawks 50,2 B posts
- 8. The ICE 1,74 Mn posts
- 9. #BeckyxCHANELCocoCrush 552 B posts
- 10. REBECCA X CHANEL LOS ANGELES 546 B posts
- 11. Jesse Watters 13,9 B posts
- 12. Noem 387 B posts
- 13. Wizards 51,6 B posts
- 14. Salt Lake City 11,2 B posts
- 15. Zcash 4.302 posts
- 16. Blazers 3.584 posts
- 17. Gestapo 134 B posts
- 18. Sharks 9.377 posts
- 19. #AEWDynamite 30,3 B posts
- 20. Deni 9.748 posts
Something went wrong.
Something went wrong.
















































































